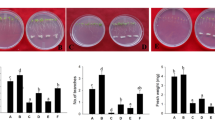

Abstract
Aims
ρ-hydroxybenzoic acid (4-HBA) is one of the major autotoxins that cause grapevine replant disease. Root border cells (RBCs) play an important role in plant defense. Although RBCs have been investigated in many plants, relevant information in grapevines is limited. In this study, we aimed to investigate the developmental characteristics of RBCs in the grapevine (Vitis riparia × Vitis labrusca) ‘Beta’ and their response to 4-HBA stress.
Methods
RBCs were observed under a laser scanning confocal microscope. The phenolic acid composition of RBCs slime was determined by high-performance liquid chromatography. The level of gene expression was determined by quantitative real-time polymerase chain reaction.
Results
Grapevine RBCs have high biological activity, contain starch granules, and are surrounded by a mucilage layer. Root treatments using different concentrations of 4-HBA affected the development of RBCs and root growth, and induced the secretion of salicylic acid from the RBCs, which can stimulate, induce, and maintain the activity of antioxidant enzymes to some extent in the cells under 4-HBA stress.
Conclusion
Grapevine RBCs may resist 4-HBA stress by increasing its number and enhancing their secondary metabolism and SA accumulation, which can induce the antioxidant defense system of the cells.
Similar content being viewed by others
Avoid common mistakes on your manuscript.
Introduction
Continuous cropping is the practice of cultivating the same crop in the same soil for many years. This usually leads to yield declines and the enrichment of soil-borne pathogens in annual crops, such as cotton (Feng et al. 2003), peanuts (Li et al. 2014; Chen et al. 2018), and potatoes (Davis et al. 1994; Lu et al. 2013). Perennial plants usually grow slowly and suffer from cropping obstacles when they are replanted (Lake et al. 1993; Henfrey et al. 2015). This phenomenon is commonly described as ‘replant disease’ or ‘continuous cropping obstacle’. ‘Replant disease’ has been reported in various fruit trees, such as apples (Mazzola 1998; Manici et al. 2013; Weiß et al. 2017), peaches (Eayre et al. 2000; Benizri et al. 2005; Yang et al. 2012), strawberries (Seigies and Pritts 2006; Zhang et al. 2008) and grapevines (Westphal et al. 2002; Cabrera et al. 2012). Grapevine replant disease is widespread in vineyards and nurseries, and significantly hinders the healthy growth of young grapevine plants. When 1–2 years old grafted plants of grapevine were replanted in the same field after the old grapevine plants have been pulled out, plants grow slowly, with short internode, small leaves and brown roots. Eventually, replant disease leads to an adverse influence on tree vigor and plant productivity.
The causes of replant problems are complex. Researchers generally believe that the causes of replant disease include: soil nutrient imbalance (Reeves 1997), rhizosphere microbial community structure disorder (Xiong et al. 2014) and allelopathic autotoxicity (Bouhaouel et al. 2014; Wu et al. 2015). Among them, rhizosphere microbial community structure and allelopathic autotoxicity are considered to play more important roles (Li et al. 2018). During growth, plant roots continuously release a series of metabolites into the rhizosphere (Iqbal and Fry 2012). Some of these metabolites can inhibit the growth of plants as autotoxins, which lead to allelopathic autotoxicity (Asao et al. 2003). Candidate allelochemicals that have been widely identified from the rhizosphere of different plants include phenolics (Gallet 1994), terpenoids (Fernandez et al. 2008), flavonoids (Hofmann et al. 2009) and alkaloids (Wink 1983). The autotoxic allelochemicals secreted by the root tips can affect the growth of replanted plants by mediating the rhizosphere microbial community (Wu et al. 2016), or directly cause damage to the physiological and biochemical characteristics of the replanted plants (Li et al. 2017a). For example, some studies have indicated that allelochemicals induce reactive oxygen species (ROS) accumulation and alter the ability of antioxidant enzymes such as superoxide dismutase (SOD), peroxidase (POD) and ascorbic acid peroxidase (APX) to respond to oxidative stress (Yu et al. 2003; Zhang et al. 2008; Cheng and Cheng 2015).
The root system is the primary site of action of autotoxic substances, and root border cells (RBCs) play a key role in plant defense as a chemical, physical, and biological interface between the roots and their surrounding environment (Hawes et al. 2000; Gunawardena and Hawes 2002). RBCs are differentiated from the apical meristem and programmed to separate from the root cap. They are defined as the cells that are released into solution within seconds of the root tips being placed into water (Hawes et al. 2000; Driouich et al. 2007). Their release requires cell wall-degrading enzymes (Wen et al. 1999). Pectin methyl esterase (PME), which catalyzes pectin demethylesterification, is one of the enzymes that has been shown to contribute to RBCs separation (Stephenson and Hawes 1994; Wen et al. 1999). Wen et al. (1999) reported that PME activity in pea root caps increased 6-fold during RBCs separation, compared with that measured after completion of the process, and the expression of corresponding PME-coding gene increased; however, when the expression of the PME gene was inhibited by antisense mRNA in a transgenic pea, RBCs separation was blocked.
Although traditionally considered to be dead cells detached from the root cap, RBCs play a key role in the root-soil interface and contribute to the properties of the root environment (Driouich et al. 2012). They provide a biotic boundary fundamental in rhizosphere modification (Watson et al. 2015), and can trap metals such as aluminum (Cai et al. 2011a; Yang et al. 2016), iron (Zhang et al. 2017), and lead (Huskey et al. 2018) by increasing the production of mucilage. Furthermore, RBCs also serve a key role in plant defense. They can attract and immobilize parasitic nematodes (Hawes et al. 2000; Wuyts et al. 2006), act as a decoy for pathogenic fungi (Kosuta et al. 2003; Jaroszuk-Sciseł et al. 2009), and repel and bind bacteria (Knox et al. 2007). In addition, they can protect the root tip from some abiotic stresses, such as high concentrations of carbon dioxide (Zhao et al. 2000). When RBCs are detached, the root cap can produce a complete set of new RBCs within 24 h (Hawes et al. 2003). Upon separation from the root cap, RBCs undergo an increase in metabolic activity. Protein synthesis and gene expression are also altered (Hawes et al. 2000) resulting in the production of specific metabolites, such as polysaccharides (Cannesan et al. 2012), secondary metabolites (Driouich et al. 2013), and proteins (Wen et al. 2007b), and forming a mucilage layer around the RBCs. This mucilage layer thickens when subjected to biotic and abiotic stresses, thereby protecting the root tip. In addition, RBCs secrete extracellular proteins and extracellular DNA (exDNA), and some of these extracellular proteins and exDNA bind to histones (Wen et al. 2009). The exDNA is synthesized and exported to the surrounding mucilage, which attracts, traps, and immobilizes pathogens in a host-microbe specific manner (Hawes et al. 2012).
To date, RBCs have been investigated in 49 plant species belonging to 14 families (Hawes et al. 2000; Chen et al. 2008), including peas (Pisum sativum L.) (Brigham et al. 1995b; Tran et al. 2016), maize (Zea mays L.) (Zhang et al. 2014; Canellas and Olivares 2017), and cucumbers (Cucumis sativus L.) (Liu and Ma 2009). However, no studies on grapevine RBCs have been performed, and it is essential to acquire knowledge on grapevine RBCs and their responses to autotoxins. Our previous research indicated that ρ-hydroxybenzoic acid (4-HBA) is one of the major autotoxins secreted by the root system of the grapevine (Guo et al. 2010, 2012, 2015). The present work aimed to (1) determine and analyze the effects of several 4-HBA treatments on the developmental characteristics, secretion characteristics, and gene expression of grapevine RBCs, and (2) preliminarily clarify the response characteristics of grapevine RBCs to autotoxicity.
Materials and Methods
Plant materials
After cold stratification, seeds from the grapevine (Vitis riparia × Vitis labrusca) ‘Beta’ were surface sterilized by immersion into 5% sodium hypochlorite solution for 20 min, and then washed five times with sterile distilled water. The floating seeds were discarded and the remaining seeds were soaked in sterile distilled water for 8 h and then transferred to an incubator at 25 °C for germination for about 7 d. After the emergence of the radicle, the seeds were transferred to growth pouches for the following experiments.
Histochemical staining and microscopy of RBCs
We used fluorescence staining and microscopic observation to observe the morphological characteristics of grapevine RBCs. Healthy roots were selected for microscopy with a Leica TCS SP8 confocal laser scanning microscope (Leica Microsystems, Wetzlar, Germany). The root tips were mounted on a microscope slide and a drop of water was added on the root tip to visualize the presence of RBCs. In order to determine the viability of the RBCs, FDA–PI (fluorescein diacetate–propidium iodide) staining was used, live cells were stained green by FDA, while dead cells were stained red by PI according to the method described by Pan et al. (2004). Briefly, the root tips were immersed in 1 mL of double distilled water (ddH2O) for 1–2 min and gently agitating with a Pasteur pipette to release the RBCs. The RBCs suspension was mixed with FDA–PI solution (FDA, 25 μg·mL−1; PI, 10 μg·mL−1) (Sigma-Aldrich, St. Louis, Missouri, USA) at a 1:1 ration and stained for 10 min in the dark. Next, 20 μL of the mixture was mounted on a microscope slide for microscopy. Fluorescein diacetate was detected by illumination with the 488-nm line of the argon laser, and emission was detected at 510 nm. Propidium iodide was detected after illumination with the 543-nm line of the argon laser, and emission was detected at 617 nm. SYTOX-Green and DAPI (4′,6-diamidino-2-phenylindole) staining were used to observe whether there are exDNA around RBCs (Wen et al. 2017), 50 μL of RBCs suspension were dispensed into two 200-μL centrifuge tubes; 1 U DNaseI (TaKaRa, Tokyo, Japan) was added to one tube and an equal volume of ddH2O was added to the other. The tubes were allowed to stand for 30 min before a 10-μL sample of the RBCs was placed onto a microscope slide. Ten microliters of 5 μM SYTOX Green (Invitrogen, Carlsbad, California, USA) or 0.5 μg·mL−1DAPI (Sigma-Aldrich) was added. After incubation for 5 min, samples were observed under a Leica TCS SP8 confocal laser-scanning microscope (Leica Microsystems). SYTOX Green was illuminated with the 345-nm laser and detected at 530 nm, while DAPI was illuminated with the 345-nm laser and detected at 460 nm. The experiment was repeated at least 10 times per treatment.
Number and viability of RBCs and thickness of mucilage layer at different root lengths
The germinated seeds were transferred to a growth pouch containing 10 mL of distilled water and incubated in the dark at 25 °C. The number and viability of RBCs and the thickness of the RBCs mucilage layer were determined when the primary roots were 10, 15, 20, 25, 30, and 35 mm long. RBCs were collected from nine primary root tips (approximately 2–3 mm of the root apex, including the root cap and apical meristem) at each root length by immersing these root tips in 50 μL distilled water for 1–2 min and then agitating the mixture with a Pasteur pipette to release the RBCs.
The number and viability of the RBCs in the resulting cell suspension was determined by staining with FDA–PI, according to the methods described above. Live (stained green, FDA fluorescence) and dead cells (stained red, PI fluorescence) were counted using a hemocytometer under a Leica TCS SP8 confocal laser scanning microscope (Leica Microsystems). The number of RBCs was the sum of live cells and dead cells. The percentage of viable cells was calculated as the number of viable RBCs divided by the total number of RBCs. This procedure was repeated nine times.
The thickness of the mucilage layer around the RBCs was measured as described in previous studies (Miyasaka and Hawes 2001; Wen et al. 2007a; Cai et al. 2011a). Briefly, 10 μL of cell suspension was mixed with 10 μL of India ink (Solarbio, Beijing, China) and observed using a Leica TCS SP8 confocal laser scanning microscope. The thickness of the mucilage layer of 10 randomly selected RBCs was measured using Image-Pro Plus 6.0 software (Media Cybernetics, Maryland, USA), and each RBC was measured in four different directions (up, down, left, and right).
Number and viability of RBCs and thickness of mucilage layer after treatment with 4-HBA
The germinated seeds were divided into four groups and transferred to growth pouches with 10 mL of different concentrations of 4-HBA (0, 50, 100, or 200 μg·mL−1), and then incubated in the dark at 25 °C for 6 d. The root length was determined every 24 h. The number and viability of the RBCs, and the thickness of the mucilage layer were determined as described above.
Extraction and activity assay of pectin methylesterase in the root cap
After treatment with different concentrations of 4-HBA for 6 d, 60 primary root tips were selected from each treatment group to extract pectin methylesterase (PME), according to the method described by Ren and Kermode (2000). The root tips were immersed in 1 mL of distilled water, agitated gently to remove the RBCs, and then placed in 200 μL of PME extraction buffer (0.1 M citrate acid, 0.2 M dibasic sodium phosphate, and 1 M sodium chloride; pH 5.0), cooled to 4 °C, and homogenized. The formed slurry was transferred to a centrifuge tube, incubated on ice for 1 h with agitation at 20 min intervals during this period, and centrifuged at 12,000×g for 10 min at 4 °C. The resulting supernatant was collected and stored at −20 °C.
Further, 10 μL of PME extract was added to 4 mL of substrate solution [0.5% (w/v) citrus pectin (Sigma-Aldrich), 0.2 M sodium chloride, 0.15% (w/v) methyl red; pH 6.8] and incubated for 2 h at 37 °C. The absorbance of the solution was measured using a spectrophotometer (Mapada, Shanghai, China) at 525 nm. A calibration curve was obtained by adding different volumes (0, 30, 60, 90, 120, 150, 180, 210, or 240 μL) of 0.01 M HCl to 4 mL of substrate solution, and measuring the absorbance of the solutions at 525 nm. The activity of PME was determined using the calibration curve, and it was expressed as μmol H+·root cap−1·h−1 (Richard et al. 1994). Each treatment was repeated three times.
Extraction and analysis of phenolic acids in the slime of RBCs
After treatment with different concentrations of 4-HBA for 6 d, root tips of 1000 main roots of seedlings were selected from each treatment group and the exudates of the RBCs were collected as follows (Brigham et al. 1995b; Wen et al. 2007b). The root tips were immersed in 2 mL of distilled water for 1–2 min, gently agitated to disperse the RBCs, and then centrifuged at 3,500×g for 30 min to obtain a pellet of RBCs and a supernatant comprising the root cap slime. The absence of cells in the supernatant was confirmed microscopically after centrifugation. After the supernatant was discarded, 1 mL of sterile water was added to the pellet, and it was incubated at room temperature for 1 h. Then the mixture containing the RBCs pellet and 1 mL of sterile water was centrifuged at 10,000×g for 10 min to obtain another RBCs pellet and RBCs slime in the supernatant. The supernatant (0.5 mL) was then added to an equal volume of methanol to determine the content of phenolic acids. The precipitate (live RBCs) and root tips were separately frozen in liquid nitrogen and stored at −80 °C until RNA extraction. The standard phenolic acids used were 4-HBA, vanillic, ferulic, benzoic, salicylic, and cinnamic acids (all Sigma-Aldrich), all of chromatographic grade. The concentration gradient of the phenolic acids was 0.075, 0.15, 0.3, 0.6, 1.2, 2.4, 4.8, 9.6, and 12 μg·mL−1. All the solutions were filtered through a 0.22-μm NELON water microporous membrane (Membrane, Michigan, USA) before analysis.
The content of phenolic acids was determined using a high-performance liquid chromatography (HPLC) instrument (Agilent Technologies, Santa Clara, California, USA) equipped with a C-18 column (250 mm × 4.6 mm, 5 μm i.d.). The mobile phase used was methanol and formic acid (0.1%), with the following gradient elution: 0–10 min, methanol 0%–5%; 10–25 min, methanol 5%–15%; 25–35 min, methanol 15%–40%; 35–40 min, methanol 40%–35%; and 40–45 min, methanol 35%–5%. The flow rate was 0.8 mL·min−1 and the wavelength was 280 nm. A variable wavelength detector was used (Hao et al. 2010). The calibration curves of the standard solutions were used in the calculation.
Analysis of gene expression
The expression of genes was determined by quantitative real-time PCR (qRT-PCR). Root tips and RBCs stored at −80 °C were used for RNA extraction, using the modified cetyl trimethylammonium bromide (CTAB) method (Guan et al. 2018). Briefly, 0.5 g of tissue was homogenized in 600 μL of 2% CTAB reagent [20 mM EDTA, 100 mM Tris-HCl (pH 8.0), 1.4 M NaCl2, and 1% PVP], mixed with 12 μL of 1% β-mercaptoethanol, and placed in a water bath for 20 min at 65 °C. The RNA was cleaned twice using equal volumes (600 μL) of chloroform mixed with isoamyl alcohol at a ratio of 24:1 (v/v) and centrifugation at 10,000×g for 10 min at 4 °C. The supernatant (400 μL) was added to 20 μL of 3 M sodium acetate and 300 μL of pre-cooled ethanol, then mixed and left to stand at −20 °C for 2 h for RNA purification. It was then centrifuged at 10,000×g for 10 min at 4 °C. The resultant supernatant was added to 100 μL of 10 mM LiCl, mixed, and allowed to stand at −20 °C for 2–6 h for RNA precipitation. The mixture was then centrifuged at 10,000×g for 10 min at 4 °C. The precipitated RNA was washed twice with pre-cooled 70% ethanol and dissolved in 20 μL of diethyl pyrocarbonate water (RNase-free). The concentration of RNA was determined using a bio-photometer at 260 nm. To determine the quality of RNA, the ratio of absorbance at 260/230 nm and 260/280 nm was calculated. Reverse transcription was performed using the Prime Script™ RT reagent kit with gDNA Eraser (TaKaRa) according to the protocol established by the manufacturer; 1 μg of RNA was used. The resulting cDNAs were used for qRT-PCR with specific primers. The sequences of key grapevine enzyme genes in the phenolic acid metabolic pathway, namely phenylalanine lyase (PAL), 4-Coumaric acid:coenzyme A ligase (4CL), and cinnamyl-CoA reductase (CCR), were retrieved from GenBank on the National Center of Biotechnological Information (NCBI) platform (https://www.ncbi.nlm.nih.gov/genbank/). Specific primers (Supplementary Table S1) were designed using Primer version 5.0 (Premier, Canada). The qRT-PCR analysis was performed using these specific primers and the cDNA of the root tips and RBCs to characterize the expression levels of candidate genes. The qRT-PCR was performed with a SYBR Premix Ex Taq™ kit (TaKaRa) using the ABI 7500 real-time PCR instrument (Applied Biosystems, Foster City, California, USA). The PCR mixture (10 μL) contained 5 μL of SYBR®Premix Ex Taq™ II (2×), 0.8 μL of each primer (10 μM), 1.0 μL of cDNA, and 2.4 μL of ddH2O. The actin gene of a grapevine was used as a reference (GenBank accession number AY680701, Guo et al. 2014; Sun et al. 2016). The relative mRNA expression was calculated according to the 2-ΔΔCT method (Livak and Schmittgen 2001). The expression of genes in the root tip of the control group was considered as the number of markers, and the value was set to 1; the expression of genes in the remaining samples was calculated. The experiment was repeated three times for each sample.
The effect of exogenous SA pretreatment on root elongation under 4-HBA treatment
After cold stratification, viable seeds were germinated as described in the previous assays. The germinated seeds were divided into two groups, transferred to growth pouches with 5 mL of 100 μM SA solution or 5 mL of distilled water, and incubated in the dark at 25 °C. After 3 d of pretreatment, equal volumes (5 mL) of 4-HBA at different concentrations (0, 50, 100, or 200 μg·mL−1) were added, and the germinated seeds were cultured for 6 d. Thus, eight treatments were applied: 0 μg·mL−1 4-HBA (T0), 50 μg·mL−1 4-HBA (T1), 100 μg·mL−1 4-HBA (T2), 200 μg·mL−1 4-HBA (T3), 100 μM SA (SA + T0), 100 μM SA + 50 μg·mL−1 4-HBA (SA + T1), 100 μM SA + 100 μg·mL−1 4-HBA (SA + T2), and 100 μM SA + 200 μg·mL−1 4-HBA (SA + T3). The root length of main roots was measured every 24 h. This experiment was performed on four biological and three technical replicates, and 20 seedlings were used per biological replicate.
The effect of exogenous SA pretreatment on the malondialdehyde content and antioxidant enzymes of seedlings under 4-HBA treatment
After cold stratification, viable seeds were germinated as described in the previous assays. The germinated seeds were sown in a matrix of peat: vermiculite: perlite at a ratio of 2:2:1. When the seedlings developed 5–6 true leaves, healthy seedlings with the same growth vigor after the removal of soil adhering to the roots, were transferred to a plastic basin (40 cm × 30 cm × 10 cm) with 5 L of distilled water. The water was aerated for 15 min at 45-min intervals using an air pump. After 2 d of adaptation, the distilled water was replaced with 1/8 Hoagland’s nutrient solution, which was replaced every 2 d for one week. The seedlings were then divided into two groups. For group 1, the nutrient solution was replaced with nutrient solution supplemented with SA, whereas seedlings in group 2 were cultured with an equal volume of SA-free nutrient solution. After 3 d, 34.5, 69, or 138 μg·mL−1 of 4-HBA was added to each group (because the seedlings had to be handled differently from the other experiment, we used different concentrations of 4-HBA). Sampling was carried out after 6 d of treatment. Leaves and roots were separated and washed with distilled water; the surface water was blotted using absorbent paper and the samples were precooled in liquid nitrogen and stored at −80 °C until the measurement of physiological indexes. This experiment was performed on four biological and three technical replicates, with four seedlings per biological replicate.
The activity of SOD was determined using the SOD assay kit (Solarbio, Beijing, China). The activities of POD, catalase (CAT), and APX were determined as described by Zhou et al. (2017), and the activity of glutathione reductase (GR) was determined according to Wang et al. (2013). The concentration of malondialdehyde (MDA) was determined according to Liu et al. (2006).
Statistical analyses
The data were analyzed using the SPSS software version 19.0 (IBM, Armonk, New York, USA). The means were compared by Student’s t test and Duncan’s multiple range test. Standard errors are provided to indicate the variations associated with particular mean values.
Results
Microscopic observations
The process of the release of RBCs in water is presented in Fig. 1. As shown, the RBCs were mainly distributed around the root cap, tightly attached to the root tip before this was subjected to any treatment (Fig. 1a). When the root tips were gently agitated after adding a drop of water, RBCs were loosened and gradually released into water (Fig. 1b-c). With a few exceptions, most of these RBCs were living cells, which means that grapevine RBCs have high viability, as determined using FDA viability staining (Fig. 1d-e). Many of the grapevine RBCs had an elongated or oval appearance, thick cell walls, and were surrounded by a mucilage layer; starch granules were clearly visible in the cytoplasm (Fig. 1f).
Root border cells (RBCs) of grapevine (Vitis riparia × Vitis labrusca) ‘Beta’ root tips. a Root tips maintained at 99% humidity in the absence of free water. b After the dispersal of cell population by gentle agitation of root tips in water. c Root cap (RC) and detached root border cells (RBCs) stained with fluorescein diacetate. d Grapevine RBCs have high viability, as determined using fluorescein diacetate viability staining. e Detection of cell viability by fluorescein diacetate-propidium iodide (Red: dead cell; Green: active cell). f Free RBCs with starch granules and mucilage layer stained with India ink. RC, root cap. Scale bars: 100 μm (a-c), 250 μm (d), 100 μm (e), 75 μm (f)
DAPI (Fig. 2a-d) and SYTOX green (Fig. 2 e-h) are DNA-specific dyes. DAPI (Fig. 2a-d) can penetrate the cell membrane and stain the nuclear DNA of living or dead cells as well as exDNA structures surrounding the RBCs, while SYTOX Green, a fluorescent dye with high affinity for nucleic acids, easily penetrates cells with damaged plasma membranes but not those with living cell membranes. Thus it can only stain the exDNA structures of living RBCs (Wen et al. 2017). When theRBCs were stained with DAPI or SYTOX Green (Fig. 2a-c, e-g), the exDNA structures (red arrows) around the RBCs were clearly observed. After treatment with DNase I, exDNA structures were not detected (Fig. 2d, h).
Visualization of extracellular DNA structure of root border cells (RBCs) of grapevine. a-c RBCs stained with DAPI. d RBCs stained with DAPI after treatment with DNase I for 30 min. e-g RBCs stained with SYTOX Green. h RBCs stained with SYTOX Green after treatment with DNase I for 30 min. White arrows indicate RBCs, red arrows indicate extracellular DNA structure surrounding RBCs, yellow arrows indicate nucleus. Scale bars: 25 μm (b, c, e), 50 μm (a, d, f, g), 75 μm (h)
Number and viability of RBCs and thickness of mucilage layer at different root lengths
With the elongation of roots up to a length of 10–35 mm, the number of RBCs produced by the root cap initially increased, and then decreased marginally (Fig. 3a). The root cap began to produce RBCs when the primary root germinated; however, the number was negligible. When the roots were 30 mm long, the number of RBCs reached the maximum, with approximately 205. In general, the viability of the RBCs was above 75% (Fig. 3b). When the roots were 15 mm long, the viability of RBCs was the highest, at 81.33%.
Influence of root length on the number and viability of root border cells (RBCs). a The number of RBCs was determined microscopically with trypan blue staining. b The viability of RBCs was determined microscopically with fluorescein diacetate-propidium iodide staining. Bars represent the mean ± SE (n = 10). Different letters indicate significant difference at p < 0.05 (Duncan’s test)
The thickness of the RBCs mucilage layers is presented in Fig. 4. The micrographs of the mucilage layer of a single RBC at different root lengths were shown in Fig. 4a. When the roots were 10 mm long, the thickness of the mucilage layer was the lowest (2.788 μm), but it gradually increased with the elongation of roots, and reached the maximum value of 9.38 μm when the roots were 30–35 mm long (Fig. 4b).
Influence of root length on the thickness of RBCs mucilage layer. a Visualization of the mucilage layers of RBCs. b The variation in the thickness of RBCs mucilage layer with root length. The thickness of the mucilage layer of RBCs was determined microscopically with India ink staining. a-1 – a-6 and b-1 – b-6 in (a) represent the variations in elongated and oval RBCs with root lengths of 10, 15, 20, 25, 30, 35 mm, respectively
ρ-Hydroxybenzoic acid promotes root growth at low concentrations, but inhibits it at high concentrations
The growth vigor of the roots of seedlings after 4-HBA-treatment is presented in Fig. 5. In the control, the root length of the seedlings increased from 5 to 55 mm during the culture period. After treatment with 200 μg·mL−1 4-HBA for 1 d, the root length of the seedlings was significantly shorter (approximately 9%) than that of the control; the roots of other treatments were not significantly different from those under the control treatment with respect to their lengths. After treatment with 200 μg·mL−1 4-HBA for 2 d, the root growth of the seedlings was significantly weaker than that of the control seedlings (approximately 42%), but treatment with 50 μg·mL−1 4-HBA significantly promoted root elongation. With the extension of treatment, this tendency increased.
Length of main roots of grapevine seedlings cultured for 6 d in water (0 μg·mL−1 4-HBA) or 4-HBA solution. Values represent the mean ± SE (n = 60). * – statistically significant differences at p < 0.05 compared with that of the control. ** – statistically significant differences at p < 0.01 compared with that of the control (Student’s t test)
ρ-Hydroxybenzoic acid treatment alters the development of RBCs
RBCs were collected from 6-d-old seedlings. The roots of the seedlings treated with 50 μg·mL−1 4-HBA released more RBCs (approximately 490 cells) than control seedlings (140 cells), increasing by 72%. After the treatment with 200 μg·mL−1 4-HBA, the number of RBCs decreased (Fig. 6a). The viability of the RBCs was maintained at a high level (approximately 79%) in the control seedlings, but it decreased significantly after the 4-HBA treatments. With increasing 4-HBA concentrations (up to 200 μg·mL−1), RBCs viability sharply decreased to 56% (Fig. 6b). The activity of PME in the root cap after the separation of RBCs initially increased, and then decreased with increasing 4-HBA concentrations, but showed no significant difference from the control (Fig. 6c).
Number (a) and viability (b) of RBCs, PME activity in the root cap (c), and thickness of the mucilage layer of RBCs (d, e) in the grapevine seedlings cultured in water (0 μg·mL−1 4-HBA) or 4-HBA solution at different concentrations. Bars represent the mean ± SE (n = 10). Different letters indicate significant difference at p < 0.05 (Duncan’s test)
Under control conditions (0 μg·mL−1 4-HBA treatment), there was a layer of mucilage around the RBCs. With the increase in 4-HBA concentration, the thickness of mucilage layer increased significantly compared with that of the control (Fig. 6d, e).
ρ-Hydroxybenzoic acid induced RBCs to secrete more phenolic acids
The 4-HBA, vanillic, benzoic, ferulic, salicylic, and cinnamic acids were selected as analytic targets. Five of these phenolic acids (all except ferulic acid) were detected in the RBCs slime. When the roots were treated with different concentrations of 4-HBA, the contents of benzoic acid and SA in the RBC slime increased significantly compared with those in the roots of control seedlings (Fig. 7). It is noteworthy that 4-HBA increased the content of SA in the RBC slime. In addition, the total amount of phenolic acids in the RBC slime increased significantly after 4-HBA treatments.
Effect of 4-HBA on the content of phenolic acids in the slime of RBCs. The abscissa are abbreviations for different phenolic acids. Benzoic acid (BA), ρ-hydroxybenzoic acid (4-HBA), vanillic acid (VA), cinnamic acid (CA), salicylic acid (SA), and total phenolic acid content (Total). Bars represent the mean ± SE (n = 3). Different letters indicate significant differences at p < 0.05 (Duncan’s test)
Expression of key enzyme genes involved in the phenolic acid metabolism pathway after 4-HBA treatments
After the detachment of RBCs from the root tip, the expression level of genes in the RBCs was significantly different from that in the root tip. After the treatment with 50 μg·mL−1 4-HBA, the expression of PAL2 was significantly up-regulated in RBCs, whereas PAL15 was significantly up-regulated in root tips. And the expression of 4CL and CCR were up-regulated by 9- and 3.3-folds in root tips. Furthermore, the treatment with 200 μg·mL−1 4-HBA inhibited the expressions of PAL1, PAL2, and PAL15 in the root tip and promoted the expression of CCR in RBCs, compared to the levels presented by control RBCs. (Fig. 8).
Exogenous SA application alleviated the inhibitory effect of 4-HBA stress on root elongation
High concentration of 4-HBA (200 μg·mL−1) exhibited a significant inhibitory effect on the growth of grapevine seedlings (Fig. 9), and exogenous SA application alleviated this inhibitory effect to some extent. After 1 d of culture, the roots of seedlings treated with 200 μg·mL−1 4-HBA were significantly shorter (approximately 2%) than those of seedlings co-treated with 100 μM SA and 200 μg·mL−1 4-HBA. This trend was increasingly evident with time; after 6 d, the roots of seedlings treated with 100 μM SA and 200 μg·mL−1 4-HBA were 77% longer than those of seedlings treated with 200 μg·mL−1 4-HBA only.
Root length of grapevine seedlings treated with 4-HBA solution or 4-HBA plus SA solution. Values represent the mean ± SE (n = 60). * – statistically significant differences at p < 0.05 compared with that of control. ** – statistically significant differences at p < 0.01 compared with that of control (Student’s t test)
Salicylic acid enhanced the activities of antioxidant enzymes and inhibited the accumulation of MDA
As the concentration of 4-HBA increased, MDA gradually accumulated in the roots. Especially after high concentration of 4-HBA (138 μg·mL−1) treatment, the MDA content in roots and leaves was significantly higher than that of the control. However, the content of MDA in the roots decreased by 9% after pretreatment with SA compared with that after 138 μg·mL−1 4-HBA treatment (Fig. 10a).
Concentration of MDA and the activity of POD, CAT, SOD, APX, and GR in grapevine seedlings treated with 4-HBA solution (-SA) or 4-HBA plus SA solution (+SA). Values represent the mean ± SE (n = 4). Different letters indicate significant difference at p < 0.05 (Duncan’s test). * and ** indicate significant difference at p < 0.05 and 0.01 between -SA and + SA, respectively (Student’s t test)
After high concentration of 4-HBA treatment (138 μg·mL−1), the POD activity of leaves and roots were significantly reduced by 28% and 54% compared with that control. Salicylic acid pretreatment significantly increased POD activity in roots by 43% compared to 4-HBA treatment alone (Fig. 10b). Then, SA pretreatment significantly activated the activity of SOD (Fig. 10c) and CAT (Fig. 10d) in roots and leaves, and remained at a high level even after 4-HBA treatment to some extent. The APX activity in roots and leaves decreased with the increase of 4-HBA concentration. Compared with 138 μg·mL−1 4-HBA treatment alone, salicylic acid pretreatment significantly increased the APX activity of roots and leaves by 66.7% and 43. %. Salicylic acid pretreatment significantly increased the activity of GR in roots, but its activity gradually decreased with the increase of 4-HBA concentration (Fig. 10e).
Discussion
Whereas the RBCs of many crops have been previously well described, RBCs characterization in the grapevine has not been reported. The present study is one of the first reports that characterizes the grapevine RBCs and its physiological response to ρ-hydroxybenzoic acid. Here, we demonstrate that grapevine RBCs response to 4-HBA by changing their metabolic properties.
Developmental characteristics of grapevine RBCs
Our study shows that grapevine RBCs were attached around the root cap (Fig. 1a) and released after the addition of distilled water (Fig. 1b, c), supporting their definition as cells that disperse in water after root-tip-immersion in this medium (Hawes and Brigham 1992). This is due to RBCs being attached to the root cap under the action of a water-soluble polysaccharide matrix; in addition, the middle lamellae of these cells are solubilized by the activity of PME in the cell wall, thus shedding in water (Wen et al. 1999; Driouich et al. 2007). We also observed that grapevine RBCs were rich in starch granules (Fig. 1e), similar to those of Medicago truncatula (Watson et al. 2015) and Solanum tuberosum (Koroney et al. 2016). Watson et al. (2015) revealed that the substantial starch deposits served as critical energy and carbon reserves for the RBCs of M. truncatula. Thus, it is likely that starch also plays an important role in the survival of grapevine RBCs after their release. Our data also show that fibrous exDNA was detected around the RBCs after staining with the DNA-specific dyes DAPI and SYTOX Green, and no exDNA was detected after treatment of the RBCs with DNaseI. Wen et al. (2009, 2017) also detected exDNA around the RBCs of Pisum sativum and Zea mays. Some studies have indicated that exDNA plays an important role in root tip defense (Hawes et al. 2011; Tran et al. 2016).
The procedures for RBCs development vary widely among plant species but are conserved at the family level (Hawes et al. 2000). The number of RBCs released from root caps is different for different species of plants. Fabaceae and Malvaceae plants produce a large number of RBCs, while Solanaceae and Brassicaceae plants produce fewer. For example, Gossypium hirsutum release 8000–10000 RBCs per 24 h, and Brassica rapa releases no RBCs (Hawes et al. 2003; Hamamoto et al. 2006). The number of RBCs produced by grapevine root tips (less than 500) is much less than that produced in legumes. In addition, the production of RBCs is also influenced by root development. The first RBCs of peas are not separated until the root is 5 mm long, and their number reaches the maximum value (~4000) when the pea root is 25 mm long (Zhao et al. 2000). The RBCs of rice (Oryza sativa L.) appear almost simultaneously with the primary roots, and the number of RBCs gradually increases with the elongation of the roots. When the root is 20 mm long, the number of RBCs is at its highest (approximately 1500). RBCs are highly active, remaining at around 85% (Cai et al. 2011b, 2011c). In the present study, RBCs were already produced when the radicle of the grapevine was 5 mm long, but in relatively low numbers (no statistical data was obtained). When the root was 30 mm long, the number of RBCs reached the maximum (approximately 205; Fig. 3a). In addition, our data show that the RBCs of grapevines had high viability, above 75% (Fig. 3b), which was consistent with pea RBCs viability (Li et al. 2017b).
ρ-Hydroxybenzoic acid affects root growth, RBCs development, and secretory properties
The most apparent effect of 4-HBA was its growth effect on grapevine roots, in which high concentrations of 4-HBA inhibited root growth, while low concentrations promoted root growth to some extent (Fig. 5). This corresponded with the changes observed in the number of RBCs (Fig. 6a). Recent studies have established that RBCs production is a tightly regulated process controlled by endogenous and environment signals, and that roots can respond to environmental changes by regulating the release of RBCs (Hawes et al. 2000; Li et al. 2007). For example, Canellas and Olivares (2017) previously reported that the release of RBCs from maize root tips was significantly increased by humic acids. After exposure of rice seedlings to iron toxicity (100 μΜ Fe2+), the number of RBCs was significantly increased (Zhang et al. 2017). In the present study, low concentration of 4-HBA (50 μg·mL−1) significantly promoted the release of RBCs, and the growth of roots was better than that of control roots. Many studies have shown that low concentrations of phenolic acids (benzoic acid, SA, etc.) can promote plant growth, while high concentrations of phenolic acids can cause toxic effects on plants (Kovácik et al. 2009; Chen et al. 2016). After the 200 μg·mL−1 4-HBA treatment, root growth restriction was evident, and a decreased number and viability of RBCs was noticed (Fig. 5; Fig. 6a, b). Soltys et al. (2014) also found a 50% reduction in the number and 15% reduction in the viability of RBCs after 3 d of cyanamide treatment, and root growth was inhibited. The decrease in the number and viability of grapevine RBCs might therefore increase the sensitivity of roots to 4-HBA.
Our data also showed the occurrence of a thick mucilage that surrounds RBCs and the layer of mucilage was thickened after 4-HBA treatment (Fig. 6d, e). After separation from the root tip, RBCs can carry out their own metabolism, and several chemical substances are secreted to coat the outer layer of the RBCs, forming a mucilage layer that protects them (Driouich et al. 2013). Many scholars are strongly convinced that RBCs can prevent damage to the root tip by increasing mucus secretion (Cai et al. 2011a, b, c; Cannesan et al. 2012; Plancot et al. 2013; Peng et al. 2015; Huskey et al. 2018). Exposure of root tips to cinnamic acid obviously increased the thickness of mucilage layer around the RBCs of cucumbers to protect the root tips from cinnamic acid toxicity (Qiao et al. 2013). The results of the present study suggesting that the increase in thickness of mucilage layer of the RBCs might be a protective physiological response to 4-HBA stress.
Hawes et al. (1998) pointed out that RBCs secrete several chemical substances such as carbohydrates, small molecules, phenols, and amino acids, after separation from the root tip, which reduces the damage of toxic substances to the root tip. This shows that the secretion of slime from RBCs is an important protective mechanism. The arabinogalactan proteins isolated from the RBCs mucilage of potatoes (Solanum tuberosum L.) was reported to play an important role in inhibiting the growth of Pectobacterium atrosepticum (a soil-borne pathogen of potatoes) (Koroney et al. 2016). Weiller et al. (2016) confirmed the presence of defensin peptides in root tissues and root border-like cells (which have been considered similar from a functional perspective to classical RBCs), as well as in mucilage, by immunomicroscopy combined with gene expression analyses. Watson et al. (2015) reported that the RBCs of M. truncatula show a pronounced enhancement in their secondary metabolism, suggesting they might play a prominent biochemical role in plant defense, plant-microbe signaling, and rhizosphere transformation. Phenolic acids are secondary metabolites of plants that are closely related to plant growth (Capriotti et al. 2015). Therefore, we determined the concentration of major phenolic acids in the mucilage of RBCs after treatment with 4-HBA and found that the total phenolic acid content and the secretion of SA and benzoic acid in the mucilage of RBCs increased. It is noteworthy that the secretion of SA significantly increased compared with that of control RBCs, and its concentration was three times higher than that of other phenolic acids.
SA is a well know endogenous plant signal molecule involved in many grown responses and in disease resistance (Raskin 1992; Dempsey et al. 1999; Park et al. 2003). Both endogenous and exogenous SA has been reported to play an important role in the plant’s antioxidant metabolism (Kang et al. 2014). Thus, we hypothesized that RBCs might play a protective role by secreting SA. Recent results show that autotoxins can induce the accumulation of ROS and alter the antioxidant system of the plant, leading to membrane lipid peroxidation and impairing the structure and function of the entire cell membrane, thereby inhibiting plant growth (Sunmonu and Staden 2014; Cheng and Cheng 2015; Ding et al. 2016). The preliminary treatment of plants with low concentrations of SA might enhance their tolerance toward most kinds of abiotic stress, due primarily to an enhanced antioxidative capacity (Wang and Li 2006; Horváth et al. 2007). In present study, after 4-HBA treatment, the amount of SA secreted by RBCs was 9.92–15.34 μg·mL−1 (equal to 71.8–110 μM). Therefore, we used 100 μM SA to pretreat hydroponic seedlings and then added 4-HBA to explore whether SA can alleviate 4-HBA stress. The results showed that the 100 μM SA pretreatment significantly activated SOD (Fig. 10c), CAT (Fig. 10d) activities in the roots of the seedlings, and even if 4-HBA was added to the hydroponic solution, the activity of these enzymes remained at a high level in the roots. These results are essentially consistent with those of previous studies. For example, 100 μM SA could induce thermotolerance in grapevine leaves by activating the activities of the antioxidant enzymes SOD, POD, APX, and GR (Wang et al. 2001; Wang and Li 2006). In contrast, high concentrations of 4-HBA (138 μg·mL−1) alone significantly inhibited POD (Fig. 10b), SOD (Fig. 10c), APX (Fig. 10f), and GR (Fig. 10e) activities in the roots, and root growth was significantly impaired. Our results suggest that exogenous addition of SA can alleviate the toxicity of 4-HBA to some extent by activating the antioxidant system of the roots. Furthermore, the concentration of exogenous SA is consistent with the amount of SA secreted by RBCs under 4-HBA stress. Therefore, we speculate that the increase of SA secretion by RBCs may be one of the ways that they respond to 4-HBA stress.
ρ-Hydroxybenzoic acid affects the expression of key secondary metabolism genes in root tip cells and RBCs
Plant secondary metabolism is closely related to its self-defense, growth and development, and signal transduction mechanisms (Wink 2016). Phenolic compounds in plants are ubiquitous as secondary metabolites and have a wide range of physiological functions. SA is one of the most common and effective endogenous signal molecules in plants. It can induce drought, salt and alkali, and low temperature resistance and it has a major regulatory effect on the growth, maturation, and senescence of plants (Metwally et al. 2003). The synthesis of SA in plants proceeds mainly through the phenylalanine pathway, which occurs in the cytoplasm (Herrmann and Weaver 1999), and through the isochorismate pathway, which occurs in the chloroplast (Kawano et al. 2004; Mustafa et al. 2009). Phenylalanine ammonia-lyase is involved in the first step of the phenylpropanoid pathway, the main pathway for the synthesis of flavonoids, lignin, stilbenes, and phenols in grapevines (Hamiduzzaman et al. 2005; Slaughter et al. 2008; Boubakri et al. 2013), which can catalyze the deamination of L-phenylalanine to trans-cinnamic acid. Benzoic acid is a direct precursor of SA synthesis, which is hydroxylated by benzoic acid 2-hydroxylase to synthesize SA (Khan et al. 2015). Accumulation of SA in plants during systemic acquired resistance is preceded by a transient increase in PAL (Smith-Becker et al. 1998). Kim and Hwang (2014) reported that the overexpression of CaPAL1 in Arabidopsis thaliana conferred increased PAL activity and SA accumulation, while CaPAL1-silenced pepper plants exhibited increased susceptibility to Xanthomonas campestris pv. vesicatoria infection, while SA accumulation and the induction of PAL activity were significantly compromised. PAL1, PAL2, and PAL15 are strongly expressed in the grapevine root (Sun et al. 2016). Thus, we determined the expression levels of these three genes in root tip tissues and RBCs after treatment with different concentrations of 4-HBA. After treatment with low concentration of 4-HBA (50 μg·mL−1), PAL2 was significantly expressed in the RBCs while PAL15 was expressed in the root tip. According to Brigham et al. (1995b) RBCs were markedly different from root tips by mRNA differential-display banding patterns, and 13% of the proteins that are abundant in RBCs are undetectable in root tip. It indicated that the gene expression patterns of RBCs and root tips were significantly different. Brigham et al. (1995a) reported that RBCs secrete slime before they are separated from the root tip. In the present study, the 50 μg·mL−1 4-HBA treatment significantly promoted phenolic compound (especially SA) secretion in RBCs, and therefore we considered that the secretion of these substances in RBCs is not only self-regulated, but also regulated by root cap cells.
Lignin is a high molecular weight secondary metabolite that plays important roles in conferring tolerance against biotic and abiotic stresses (Nguyen et al. 2016). It is widely accumulated during plant development and is mainly produced by the phenylpropanoid metabolic pathway. 4-Coumaric acid:coenzyme A ligase (4CL) and cinnamoyl-CoA reductase (CCR) are key enzymes in this metabolic pathway. Cinnamoyl-CoA reductase is the first rate-limiting enzyme that catalyzes the lignin-specific pathway. Dixon and Lamb (1990) indicated that the lignification of the plant cell wall might promote plants’ resistance to stresses. When the leaves of A. thaliana were infected with bacteria, the expression of AtCCR2 regulated the resistance of the plant to disease. Furthermore, AtCCR2 is considered to be involved in the synthesis of phenolic compounds that participate in disease resistance and in the formation of lignin to promote disease and stress resistance (Lauvergeat et al. 2001). 4-Coumaric acid:coenzyme A ligase (4CL) induces phenylpropanoid metabolism to lignin biosynthesis and plays a key role in plant responses to external stresses. After induction at high temperature (40 °C), the expression of Gp4CL in Gnetum parvifolium continued to increase for 48 h (Nan et al. 2016). In the present study, after treatment with 4-HBA, the expression of CCR in the RBCs was significantly increased. There was a layer of lignified cell wall around the RBCs under normal conditions, probably because the treatment with 4-HBA induced a stress response in the cells and promoted the lignification of cell walls to resist the penetration of stress substances. The expression of 4CL in the root tips and RBCs treated with a low concentration of 4-HBA (50 μg·mL−1) increased, especially the expression of 4CL in the root tips. In addition, the expression of CCR in the RBCs was significantly correlated with the content of SA in the RBCs slime (Supplementary Table S3). Zhou et al. (2018) reported that SA effectively enhanced the activity of phenylpropanoid pathway-related enzymes, in the process of inducing citrus fruit disease resistance, and stimulated the synthesis of phenolic acid and its metabolite lignin. Thus, as a signaling molecule, SA can exert an anti-reverse effect by inducing plants to synthesize phenolic acid and lignin. Therefore, we hypothesized that 4-HBA stimulated the synthesis and secretion of SA, thereby enhancing the secondary metabolism of RBCs to exert its anti-reverse effects.
Conclusion
The present study revealed the developmental characteristics of grapevine RBCs and a possible mechanism by which RBCs respond to 4-HBA stress. Low concentrations of 4-HBA promoted root growth and the release of RBCs, whereas high concentrations showed opposite trends. Overall, 4-HBA induced the secretion of slime by RBCs, in which the SA contents were significantly promoted, and secondary metabolic-related enzyme genes were also affected, especially the PAL gene in root tips and RBCs. Exogenous SA can alleviate 4-HBA stress by inducing the antioxidant enzyme system of plants. Therefore, the present results suggest that RBCs might resist 4-HBA stress by enhancing their secondary metabolism, leading to SA accumulation, which induces the antioxidant defense system of the cells.
Abbreviations
- 4-HBA:
-
ρ-hydroxybenzoic acid
- RBCs:
-
Root border cells
- HPLC:
-
High-performance liquid chromatography
- SA:
-
Salicylic acid
- exDNA:
-
Extracellular DNA
- PME:
-
Pectin methylesterase
References
Asao T, Hasegawa K, Sueda Y, Tomita K, Taniguchi K, Hosoki T et al (2003) Autotoxicity of root exudates from taro. Sci Hortic 97:389–396
Benizri E, Piutti S, Verge S, Loïc P, Vercambre G, Poessel JL et al (2005) Replant diseases: bacterial community structure and diversity in peach rhizosphere as determined by metabolic and genetic fingerprinting. Soil Biol Biochem 37:1738–1746
Boubakri H, Poutaraud A, Wahab MA, Clayeux C, Baltenweckguyot R, Steyer D et al (2013) Thiamine modulates metabolism of the phenylpropanoid pathway leading to enhanced resistance to plasmopara viticola in grapevine. BMC Plant Biol 13:31
Bouhaouel I, Gfeller A, Fauconnier ML, Rezgui S, Amara HS, Jardin P (2014) Allelopathic and autotoxicity effects of barley (Hordeum vulgare L. ssp. vulgare) root exudates. BioControl 60:425–436
Brigham LA, Woo HH, Hawes MC (1995a) Root border cells as tools in plant cell studies. Methods Cell Biol 49:377–387
Brigham LA, Woo HH, Nicoll SM, Hawes MC (1995b) Differential expression of proteins and mRNAs from border cells and root tips of pea. Plant Physiol 109:457–463
Cabrera JA, Wang D, Schneider SM, Hanson BD (2012) Subsurface drip application of alternative fumigants to methyl bromide for controlling nematodes in replanted grapevines. Pest Manag Sci 68:773–780
Cai MZ, Wang FM, Li RF, Zhang SN, Wang N, Xu GD (2011a) Response and tolerance of root border cells to aluminum toxicity in soybean seedlings. J Inorg Biochem 105:966–971
Cai MZ, Zhang SN, Xing CH, Wang FM, Lei Z, Ning W et al (2011b) Interaction between iron plaque and root border cells ameliorates aluminum toxicity of Oryza sativa differing in aluminum tolerance. Plant Soil 353:155–167
Cai MZ, Zhang SN, Xing CH, Wang FM, Ning W, Lei Z (2011c) Developmental characteristics and aluminum resistance of root border cells in rice seedlings. Plant Sci 180:702–708
Canellas LP, Olivares FL (2017) Production of border cells and colonization of maize root tips by Herbaspirillum seropedicae are modulated by humic acid. Plant Soil 417:403–413
Cannesan MA, Durand C, Burel C, Gangneux C, Lerouge P, Ishii T et al (2012) Effect of arabinogalactan proteins from the root caps of pea and Brassica napus on Aphanomyces euteiches zoospore chemotaxis and germination. Plant Physiol 159:1658–1670
Capriotti AL, Cavaliere C, Foglia P, Piovesana S, Ventura S (2015) Chromatographic methods coupled to mass spectrometry detection for the determination of phenolic acids in plants and fruits. J Liq Chromatogr Relat Technol 38:353–370
Chen W, Liu P, Xu GD, Cai MZ, Yu H, Chen M (2008) Effects of Al3+on the biological characteristics of cowpea root border cells. Acta Physiol Plant 30:303–308
Chen E, Zhang DH, Wang DD, Jin H, Li XZ, He XF et al (2016) Allelopathic effect and mechanism of action of three phenolic acids on lettuce seedlings. Chinese J Pesticide Sci 18:317–322
Chen W, Teng Y, Li Z, Liu W, Ren W, Luo Y et al (2018) Mechanisms by which organic fertilizer and effective microbes mitigate peanut continuous cropping yield constraints in a red soil of South China. Appl Soil Ecol 128:23–34
Cheng F, Cheng ZH (2015) Research progress on the use of plant allelopathy in agriculture and the physiological and ecological mechanisms of allelopathy. Front Plant Sci 6:1020
Davis JR, Pavek JJ, Corsini DL, Sorensen LH, Schneider AT, Everson DO et al (1994) Influence of continuous cropping of several potato clones on the epidemiology of verticillium wilt of potato. Phytopathology 84:207–214
Dempsey DMA, Shah J, Klessig DF (1999) Salicylic acid and disease resistance in plants. Crit Rev Plant Sci 18:547–575
Ding HY, Cheng ZH, Liu ML, Hayat S, Feng H (2016) Garlic exerts allelopathic effects on pepper physiology in a hydroponic co-culture system. Biol Open 5:631–637
Dixon RA, Lamb CJ (1990) Molecular communication in interactions between plants and microbial pathogens. Annu Rev Plant Biol 41:339–367
Driouich A, Durand C, Vicré-Gibouin M (2007) Formation and separation of root border cells. Trends Plant Sci 12:14–19
Driouich A, Cannesan MA, Dardelle F, Durand C, Plancot B, Bernard S et al (2012) Unity is strength: the power of border cells and border-like cells in relation with plant defense. In: Secretions and exudates in biological systems. Springer, pp 91–107
Driouich A, Follet-Gueye ML, Vicré-Gibouin M, Hawes MC (2013) Root border cells and secretions as critical elements in plant host defense. Curr Opin Plant Biol 16:489–495
Eayre CG, Sims JJ, Ohr HD, Mackey B (2000) Evaluation of methyl iodide for control of peach replant disorder. Plant Dis 84:1177–1179
Feng Y, Motta AC, Reeves DW, Burmester CH, Osborne JA (2003) Soil microbial communities under conventional-till and no-till continuous cotton systems. Soil Biol Biochem 35:1693–1703
Fernandez C, Sébastien V, Jean-Philippe M, Vila B, Ormeño E, Dupouyet S et al (2008) Regeneration failure of pinus halepensis mill.: the role of autotoxicity and some abiotic environmental parameters. For Ecol Manag 255:2928–2936
Gallet C (1994) Allelopathic potential in bilberry-spruce forests: influence of phenolic compounds on spruce seedlings. J Chem Ecol 20:1009–1024
Guan L, Zhao MZ, Wang QL, Wu WM, Qian YM, Wu JH (2018) Improved CTAB method for extracting RNA from different tissues of fruit trees. Jiangsu Agricultural Sciences 46:19–22 (in Chinese)
Gunawardena U, Hawes MC (2002) Tissue specific localization of root infection by fungal pathogens: role of root border cells. Mol Plant-Microbe Interact 15:1128–1136
Guo XW, Li K, Sun YN, Zhang LH, Hu XX, Xie HG (2010) Allelopathic effects and identification of allelochemicals in grape root exudates. Acta Horticulturae Sinica 37:861–868 (in Chinese with English abstract)
Guo XW, Li N, Li K, Guo YS, Li CX, Xie HG (2012) Initial isolation and identification of the main toxic material in root exudation of Vitis vinifera. J Fruit Sci 29:861–866 (in Chinese with Engish abstract)
Guo CL, Guo RR, Xu XZ, Gao M, Li XQ, Song JY et al (2014) Evolution and expression analysis of the grape (vitis vinifera L.) WRKY gene family. J Exp Bot 65:1513–1528
Guo XW, Wang B, Li K, Liu ZD, Han X, Xu SJ et al (2015) Effect of 4-hydroxybenzoic acid on grape (Vitis vinifera L.) soil microbial community structure and functional diversity. Biotechnol Biotechnol Equip 29:637–645
Hamamoto L, Hawes MC, Rost TL (2006) The production and release of living root cap border cells is a function of root apical meristem type in dicotyledonous angiosperm plants. Ann Bot 97:917–923
Hamiduzzaman MM, Jakab G, Barnavon L, Neuhaus JM, Mauch-Mani B (2005) β- aminobutyric acid-induced resistance against downy mildew in grapevine acts through the potentiation of callose formation and jasmonic acid signaling. Mol Plant-Microbe Interact 18:819–829
Hao WY, Ren LX, Ran W, Shen QR (2010) Allelopathic effects of root exudates from watermelon and rice plants on Fusarium oxysporum f.sp. niveum. Plant Soil 336:485–497
Hawes MC, Brigham LB (1992) Impact of root border cells on microbial populations in the rhizosphere. Plant Pathol 8:119–148
Hawes MC, Brigham LA, Wen F, Woo HH, Zhu Y (1998) Function of root border cells in plant health: pioneers in the rhizosphere. Annu Rev Phytopathol 36:311–327
Hawes MC, Gunawardena U, Miyasaka S, Zhao X (2000) The role of root border cells in plant defense. Trends Plant Sci 5:128–133
Hawes MC, Bengough G, Cassab G, Ponce G (2003) Root caps and rhizosphere. J Plant Growth Regul 21:352–367
Hawes MC, Curlango-Rivera G, Wen F, White GJ, Vanetten HD, Xiong Z (2011) Extracellular dna: the tip of root defenses? Plant Sci 180:741–745
Hawes MC, Curlango-Rivera G, Xiong Z, Kessler JO (2012) Roles of root border cells in plant defense and regulation of rhizosphere microbial populations by extracellular DNA ‘trapping’. Plant Soil 355:1–16
Henfrey JL, Baab G, Schmitz M (2015) Physiological stress responses in apple under replant conditions. Sci Hortic 194:111–117
Herrmann KM, Weaver LM (1999) The shikimate pathway. Annu Rev Plant Physiol Plant Mol Biol 50:473–503
Hofmann A, Wittenmayer L, Arnold G, Schieber A, Merbach W (2009) Root exudation of phloridzin by apple seedlings (Malus × domestica Borkh.) with symptoms of apple replant disease. J Appl Bot Food Qual 82:193–198
Horváth E, Szalai G, Janda T (2007) Induction of abiotic stress tolerance by salicylic acid signalling. J Plant Growth Regul 26:290–300
Huskey DA, Curlango-Rivera G, Root RA, Wen F, Amistadi MK, Chorover J et al (2018) Trapping of lead (pb) by corn and pea root border cells. Plant Soil 430:205–217
Iqbal A, Fry S (2012) Potent endogenous allelopathic compounds in Lepidium sativum seed exudate: effects on epidermal cell growth in Amaranthus caudatus seedlings. J Exp Bot 63:2595–2604
Jaroszuk-Sciseł J, Kurek E, Rodzik B, Winiarczyk K (2009) Interactions between rye (Secale cereale) root border cells (RBCs) and pathogenic and nonpathogenic rhizosphere strains of Fusarium culmorum. Mycol Res 113:1053–1061
Kang G, Li G, Guo T (2014) Molecular mechanism of salicylic acid-induced abiotic stress tolerance in higher plants. Acta Physiol Plant 36:2287–2297
Kawano T, Furuichi T, Muto S (2004) Controlled salicylic acid levels and corresponding signaling mechanisms in plants. Plant Biotechnology 21:319–335
Khan MIR, Fatma M, Per TS, Anjum NA, Khan NA (2015) Salicylic acid-induced abiotic stress tolerance and underlying mechanisms in plants. Front Plant Sci 6:462
Kim DS, Hwang BK (2014) An important role of the pepper phenylalanine ammonia-lyase gene (PAL1) in salicylic acid-dependent signalling of the defence response to microbial pathogens. J Exp Bot 65:2295–2306
Knox OGG, Gupta VVSR, Nehl DB, Stiller WN (2007) Constitutive expression of cry proteins in roots and border cells of transgenic cotton. Euphytica 154:83–90
Koroney AS, Plasson C, Pawlak B, Sidikou R, Driouich A, Menubouaouiche L (2016) Root exudate of Solanum tuberosum is enriched in galactose-containing molecules and impacts the growth of Pectobacterium atrosepticum. Ann Bot 118:797–808
Kosuta S, Chabaud M, Lougnon G, Gough C, Dénarié J, Barker DG et al (2003) A diffusible factor from arbuscular mycorrhizal fungi induces symbiosis-specific MtENOD11 expression in roots of Medicago truncatula. Plant Physiol 131:952–962
Kovácik J, Grúz J, Backor M, Strnad M, Repcák M (2009) Salicylic acid-induced changes to growth and phenolic metabolism in Matricaria chamomilla plants. Plant Cell Rep 28:135–143
Lake RJ, Falloon PG, Cook DWM (1993) Replant problem and chemical components of asparagus roots. N Z J Crop Hortic Sci 21:53–58
Lauvergeat V, Lacomme C, Lacombe E, Lasserre E, Roby D, Grima-Pettenati J (2001) Two cinnamoyl-CoA reductase (CCR) genes from Arabidopsis thaliana, are differentially expressed during development and in response to infection with pathogenic bacteria. Phytochemistry 57:1187–1195
Li RF, Cai MZ, Liu P, Xu GD, He L (2007) Physiological and ecological response of the root border cells to aluminum toxicity in soybean. Acta Ecol Sin 27:4182–4190
Li XG, Ding CF, Zhang TL, Wang XX (2014) Fungal pathogen accumulation at the expense of plant-beneficial fungi as a consequence of consecutive peanut monoculturing. Soil Biol Biochem 72:11–18
Li M, Yang Y, Feng F, Zhang B, Chen S, Yang C et al (2017a) Differential proteomic analysis of replanted Rehmannia glutinosa roots by iTRAQ reveals molecular mechanisms for formation of replant disease. BMC Plant Biol 17:116
Li XW, Liu JY, Fang J, Tao L, Shen RF, Li YL et al (2017b) Boron supply enhances aluminum tolerance in root border cells of pea (Pisum sativum) by interacting with cell wall pectins. Front Plant Sci 8:742
Li XG, Jousset A, De Boer W, Carrión VJ, Zhang TL, Wang XX et al (2018) Legacy of land use history determines reprogramming of plant physiology by soil microbiome. The ISME J 13:738–751
Liu S, Ma DW (2009) The allelopathy of different development stages of Amaranthus retroflexus L. on root border cells of cucumber. Acta Ecol Sin 29:4392–4396
Liu P, Yang YS, Xu G, Guo S, Zheng X, Wang M (2006) Physiological responses of four herbaceous plants to aluminum stress in South China. Frontiers of Biology in China 1:295–302
Livak KJ, Schmittgen TD (2001) Analysis of relative gene expression data using real-time quantitative PCR and the 2-ΔΔCT method. Methods 25:402–408
Lu L, Yin S, Liu X, Zhang W, Gu T, Shen Q et al (2013) Fungal networks in yield-invigorating and -debilitating soils induced by prolonged potato monoculture. Soil Biol Biochem 65:186–194
Manici LM, Kelderer M, Franke-Whittle IH, Rühmer T, Naef A (2013) Relationship between root-endophytic microbial communities and replant disease in specialized apple growing areas in europe. Appl Soil Ecol 72:207–214
Mazzola M (1998) Elucidation of the microbial complex having a causal role in the development of apple replant disease in Washington. Phytopathology 88:930–938
Metwally A, Finkemeier I, Georgi M, Dietz KJ (2003) Salicylic acid alleviates the cadmium toxicity in barley seedlings. Plant Physiol 132:272–281
Miyasaka S, Hawes MC (2001) Possible role of root border cells in detection and avoidance of aluminum toxicity. Plant Physiol 125:1978–1987
Mustafa NR, Hyekyong K, Younghae C, Erkelens C, Lefeber AWM, Spijksma G et al (2009) Biosynthesis of salicylic acid in fungus elicited Catharanthus roseus cells. Phytochemistry 70:532–539
Nan D, Chang E, Li M, Jing J, Yao X, Bartish IV et al (2016) Transcriptome characterization of Gnetum parvifolium reveals candidate genes involved in important secondary metabolic pathways of flavonoids and stilbenoids. Front Plant Sci 7:174
Nguyen TN, Son SH, Jordan MC, Levin DB, Ayele BT (2016) Lignin biosynthesis in wheat (Triticum aestivum L.): its response to waterlogging and association with hormonal levels. BMC Plant Biol 16:28
Pan JW, Ye D, Wang LL, Hua J, Zhao GF, Pan WH et al (2004) Root border cell development is a temperature-insensitive and Al-sensitive process in barley. Plant Cell Physiol 45:751–760
Park YS, Min HJ, Ryang SH, Oh KJ, Cha JS, Kim HY, Cho TJ (2003) Characterization of salicylic acid-induced genes in Chinese cabbage. Plant Cell Rep 21:1027–1034
Peng C, Wang Y, Sun L, Xu C, Zhang L, Shi J (2015) Distribution and speciation of cu in the root border cells of rice by STXM combined with NEXAFS. Bull Environ Contam Toxicol 96:408–414
Plancot B, Santaella C, Jaber R, Kiefermeyer MC, Folletgueye ML, Leprince J et al (2013) Deciphering the responses of root border-like cells of arabidopsis and flax to pathogen-derived elicitors. Plant Physiol 163:1584–1597
Qiao YX, Zhang YP, Zhang HX, Tian YQ, Gao LH (2013) Developmental characteristics and cinnamic acid resistance of root border cells in cucumber and figleaf gourd seedlings. J Integr Agric 12:2065–2073
Raskin I (1992) Role of salicylic acid in plants. Annu Rev Plant Physiol Plant Mol Biol 43:439–463
Reeves DW (1997) The role of soil organic matter in maintaining soil quality in continuous cropping systems. Soil Tillage Res 43:131–167
Ren C, Kermode AR (2000) An increase in pectin methyl esterase activity accompanies dormancy breakage and germination of yellow cedar seeds. Plant Physiol 124:231–242
Richard L, Qin LX, Gadal P, Goldberg R (1994) Molecular cloning and characterisation of a putative pectin methylesterase cDNA in Arabidopsis thaliana (L.). FEBS Lett 355:135–139
Seigies AT, Pritts M (2006) Cover crop rotations alter soil microbiology and reduce replant disorders in strawberry. Hortscience A Publication of the American Society for Horticultural Science 41:1303–1308
Slaughter A, Hamiduzzaman MM, Gindro K, Neuhaus JM, Mauch-Mani B (2008) Beta-aminobutyric acid-induced resistance in grapevine against downy mildew: involvement of pterostilbene. Eur J Plant Pathol 122:185–195
Smith-Becker J, Marois E, Huguet EJ, Midland SL, Sims JJ, Keen NT (1998) Accumulation of salicylic acid and 4-hydroxybenzoic acid in phloem fluids of cucumber during systemic acquired resistance is preceded by a transient increase in phenylalanine ammonia-lyase activity in petioles and stems. Plant Physiol 116:231–238
Soltys D, Rudzińska-Langwald A, Kurek W, Szajko K, Sliwinska E, Bogatek R et al (2014) Phytotoxic cyanamide affects maize (Zea mays) root growth and root tip function: from structure to gene expression. J Plant Physiol 171:565–575
Stephenson M, Hawes MC (1994) Correlation of pectin methylesterase activity in root caps of pea with brder cell separation. Plant Physiol 106:739–745
Sun RZ, Zhang X, Cheng G, Qiang LI, Zhu YR, Chen W et al (2016) Genome-wide characterization and expression analysis of the phenylalanine ammonia-lyase gene family in grapevine (Vitis vinifera L.). Plant Physiology J 2:195–208
Sunmonu TO, Staden JV (2014) Phytotoxicity evaluation of six fast-growing tree species in South Africa. S Afr J Bot 90:101–106
Tran TM, Macintyre A, Hawes MC, Allen C (2016) Escaping underground nets: extracellular DNases degrade plant extracellular traps and contribute to virulence of the plant pathogenic bacterium Ralstonia solanacearum. PLoS Pathog 12:e1005686
Wang LJ, Li SH (2006) Thermotolerance and related antioxidant enzyme activities induced by heat acclimation and salicylic acid in grape (Vitis vinifera L.) leaves. Plant Growth Regul 48:137–144
Wang LJ, Huang WD, Yu FY (2001) Effects of elevated temperature on transportation and distribution of 14C-salicylic acid in grape seedlings. Acta Phytophysiologica Sinica 27:129–134
Wang P, Sun X, Li C, Wei ZW, Liang D, Ma FW (2013) Long-term exogenous application of melatonin delays drought-induced leaf senescence in apple. J Pineal Res 54:292–302
Watson BS, Bedair M, Urbanczyk-Wochniak E, Huhman DV, Yang DS, Allen SN et al (2015) Integrated metabolomics and transcriptomics reveal enhanced specialized metabolism in Medicago truncatula root border cells. Plant Physiol 167:1699–1716
Weiller F, Moore JP, Young P, Driouich A, Vivier MV (2016) The brassicaceae species Heliophila coronopifolia produces root border-like cells that protect the root tip and secrete defensin peptides. Ann Bot 119:803
Weiß S, Liu B, Reckwell D, Beerhues L, Winkelmann T (2017) Impaired defense reactions in apple replant disease-affected roots of malus domestica 'M26'. Tree Physiol 37:1–14
Wen F, Zhu Y, Hawes MC (1999) Effect of pectin methylesterase gene expression on pea root development. Plant Cell 11:1129–1140
Wen F, Curlango-Rivera G, Hawes MC (2007a) Proteins among the polysaccharides: a new perspective on root cap slime. Plant Signal Behav 2:410–412
Wen F, Vanetten HD, Tsaprailis G, Hawes MC (2007b) Extracellular proteins in pea root tip and border cell exudates. Plant Physiol 143:773–783
Wen F, White GJ, Vanetten HD, Xiong ZG, Hawes MC (2009) Extracellular DNA is required for root tip resistance to fungal infection. Plant Physiol 151:820–829
Wen F, Curlango-Rivera G, Huskey DA, Xiong Z, Hawes MC (2017) Visualization of extracellular dna released during border cell separation from the root cap. Am J Bot 104:1–9
Westphal A, Browne GT, Schneider S (2002) Evidence for biological nature of the grape replant problem in California. Plant Soil 242:197–203
Wink M (1983) Inhibition of seed germination by quinolizidine alkaloids: aspects of allelopathy in Lupinus albus L. Planta 158:365–368
Wink M (2016) Secondary metabolites, the role in plant diversification of. In: Encyclopedia of evolutionary biology, In, pp 1–9
Wu B, Long QL, Gao Y, Wang Z, Shao TW, Liu YN et al (2015) Comprehensive characterization of a timecourse transcriptional response induced by autotoxins in Panax ginseng using RNA-Seq. BMC Gnomics 16:1010
Wu L, Wang J, Huang W, Wu H, Chen J, Yang Y et al (2016) Corrigendum: plant-microbe rhizosphere interactions mediated by rehmannia glutinosa root exudates under consecutive monoculture. Sci Rep 5:15871
Wuyts N, Maung ZTZ, Swennen R, Waele DD (2006) Banana rhizodeposition: characterization of root border cell production and effects on chemotaxis and motility of the parasitic nematode Radopholus similis. Plant Soil 283:217–228
Xiong W, Zhao QY, Zhao J, Xun WB, Li R, Zhang RF et al (2014) Different continuous cropping spans significantly affect microbial community membership and structure in a vanilla-grown soil as revealed by deep pyrosequencing. Microb Ecol 70:209–218
Yang JI, Ruegger PM, Mckenry MV, Becker JO, Borneman J (2012) Correlations between root-associated microorganisms and peach replant disease symptoms in a California soil. PLoS One 7:e46420
Yang J, Qu M, Fang J, Shen RF, Feng YM, Liu JY, et al. (2016) Alkali-soluble pectin is the primary target of aluminum immobilization in root border cells of pea (Pisum sativum). Front Plant Sci 7: 1297
Yu JQ, Ye SF, Zhang MF, Hu WH (2003) Effects of root exudates and aqueous root extracts of cucumber (Cucumis sativus) and allelochemicals, on photosynthesis and antioxidant enzymes in cucumber. Biochem Syst Ecol 31:129–139
Zhang Y, Hu T, Ji L, Cao K (2008) A bio-product as alternative to methyl bromide for replant disease control on strawberry. Front Agric China 2:72–76
Zhang Y, Chen B, Gao S, Rong T (2014) Biological characters of root border cells development in maize (Zea mays). Biotechnology 13:89–98
Zhang Y, Wu YH, Xu GD, Song JM, Wu TG, Mei XM et al (2017) Effects of iron toxicity on the morphological and biological characteristics of rice root border cells. J Plant Nutr 40:332–343
Zhao XW, Misaghi IJ, Hawes MC (2000) Stimulation of border cell production in response to increased carbon dioxide levels. Plant Physiol 122:181–188
Zhou J, Wan H, He J, Lyu D, Li H (2017) Integration of cadmium accumulation, subcellular distribution, and physiological responses to understand cadmium tolerance in apple root stocks. Front Plant Sci 8:966
Zhou Y, Ma J, Xie J, Deng L, Yao S, Zeng K (2018) Transcriptomic and biochemical analysis of highlighted induction of phenylpropanoid pathway metabolism of citrus fruit in response to salicylic acid, pichia membranaefaciens and oligochitosan. Postharvest Biol Technol 142:81–92
Acknowledgements
This work was supported by the National Natural Science Foundation of China (31101503; 31572076), the Ministry of Education of the Liaoning Province of China (Grant 2015493), the Special Foundation of China Agricultural Research System (CARS-29-yc-6), and the Distinguished Middle-Aged and Young Scientist Encourage and Reward Foundation of Shenyang City (RC170467).
Author information
Authors and Affiliations
Corresponding authors
Additional information
Responsible Editor: Hans Lambers.
Publisher’s note
Springer Nature remains neutral with regard to jurisdictional claims in published maps and institutional affiliations.
Electronic supplementary material
ESM 1
(DOCX 33 kb)
Rights and permissions
About this article
Cite this article
Liu, Q., Li, K., Guo, X. et al. Developmental characteristics of grapevine seedlings root border cells and their response to ρ-hydroxybenzoic acid. Plant Soil 443, 199–218 (2019). https://doi.org/10.1007/s11104-019-04220-9
Received:
Accepted:
Published:
Issue Date:
DOI: https://doi.org/10.1007/s11104-019-04220-9